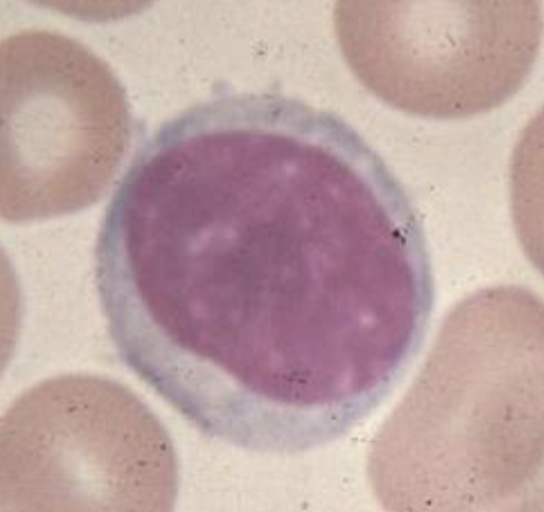

bodys lines of defense, which are specific?
- Barriers – skin, mucous membranes, secretions
- Inflammatory Response – cells (leukocytes),
molecules (mediators) - Immune Response – only one that is specific
Antibodies (humoral),
Cytotoxic T cells (cellular)
Antigen (Ag) -
Antigen (Ag) - A substance that can induce an
immune response when introduced into an
animal.
Antibody (Ab)
Antibody (Ab) - A protein that is produced in
response an antigen. The antibody binds the
antigen that stimulated its production. All
antibodies are immunoglobulins.
Immunoglobulin (Ig) -
Immunoglobulin (Ig) - A glycoprotein composed
of heavy and light chains that functions as an
antibody.
Schematic Structure of a Typical Immunoglobulin (Antibody) Molecule

• IgM -
• IgM - first immunoglobulin to
appear in an immune response
IgG -
IgG - principal immunoglobulin of the secondary immune response.
Only immunoglobulin capable of crossing the placental barrier
IgA -
IgA - principal immunoglobulin in
external secretions of mucosal
surfaces, tears, saliva, and
colostrum
IgE -
IgE - plays an important role in
immediate hypersensitivity
reactions and parasitic infections
IgD
gD - thought to activate the B-
lymphocyte
lymphocyte
Primary and Secondary Lymphoid Organs
• All lymphocytes arise in the bone marrow
• Primary lymphoid organs
– Bone marrow
– Thymus
• Secondary lymphoid organs
– Lymph nodes
– Tonsils
– Spleen
– Mucosal-associated lymphoid tissue (MALT)
Subsets of
Lymphocytes
B and T
distinguishing b and t cells
There are two
types of
lymphocytes, B
cells and T cells
• They look alike in
their H&E
phenotype, but
they are
completely
different
B lymphocytes become? role?
plasma cells
secrete antibodies when
challenged by antigen
• Antibodies are essential
for humoral immunity
Agammaglobulinemia (Bruton Agammaglobulinemia)
inheritence?
more common in?
type of dx?
result?
deficeint in what immune function?
susceptiable to?
tx?
- X-linked genetic disease – more common in males
- X-linked agammaglobulinemia (XLA)
- A primary immunodeficiency disease
- B lymphocytes unable to mature to plasma cells
- Can’t make antibody and are deficient in opsonization
- Recurrent bacterial infections
- Treatment: intravenous infusions of immunoglobulin every 3-4 weeks for life (passive immunity)
QB of IS?
Tcells (CD4)
types of t cells
T Lymphocytes
• CD4+ (T Helper Cell) - quarterback
• CD8+( Cytotoxic T Cell) - effector
role of t cells
• Cell-mediated defense against intracellular pathogens
– Viruses, fungi and one important bacterial disease (tuberculosis)
Natural Killer Cell
• A component of the innate immune system
• A type of cytotoxic lymphocyte
• Do not have markers for B or T cells
Function of the Thymus
• T cells become educated
• Learn self from non-self
• Self-reacting T cells are
deleted
Lymph Nodes and lymphocytes
• B lymphocytes leave the bone
marrow and populate lymph nodes
• T lymphocytes leave the thymus and populate lymph nodes
IS balance
• Self / non-self recognition
• General / specific
• Natural / adaptive
• Innate / acquired
• Humoral / cell-mediated
• Active / passive
• Primary / secondary
classifications of pathogens, examples and immunity responsible for defense
• Extracellular pathogens
– Most bacteria
– Humoral immunity
• Intracellular pathogens
– Viruses, fungi, some bacteria
– Cellular immunity


















